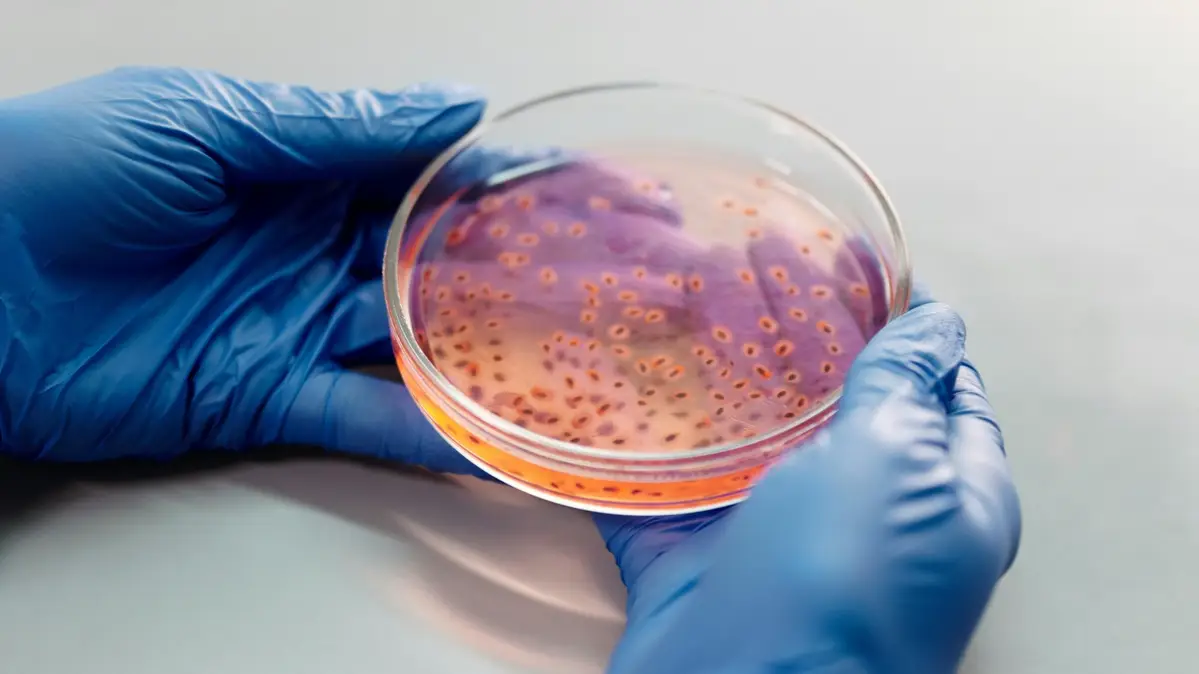

Updated 6 February 2025 at 08:21 IST
Mouth Bacteria Linked To An Increased Risk Of Alzheimer's Disease: Know More
While certain mouth bacteria can boost memory and attention, others were linked to an increased risk of Alzheimer’s disease.
- Health News
- 2 min read
Mouth Bacteria: Amid a global spike in cases of Alzheimer’s disease, a study on Wednesday showed that the bacteria in the mouth and on the tongue can indicate the risk of poor brain function and the underlying neurodegenerative disease.
While certain mouth bacteria can boost better memory and attention, others were linked to an increased risk of Alzheimer’s disease, said the researchers from the University of Exeter, in the UK.
The researchers found that the harmful bacteria may impact the brain by directly entering the bloodstream, potentially causing damage to the brain. Alternatively, it can also cause an imbalance between beneficial and harmful bacteria.
This will reduce the conversion of nitrate (abundant in vegetable-rich diets) to nitric oxide — a chemical crucial for brain communication and memory formation.
Advertisement
“Our findings suggest that some bacteria might be detrimental to brain health as people age,” said lead author Dr Joanna L’Heureux, of the University of Exeter Medical School. L’Heureux urged “for performing routine tests as part of dental checkups to measure bacterial levels and detect very early signs of declining brain health”.
The study, published in the journal PNAS Nexus, recruited 110 participants, over the age of 50 from an online study that tracks brain health. The team analysed mouth rinse samples and studied the bacteria population in them.
Advertisement
The results showed that people with large numbers of the bacteria groups Neisseria and Haemophilus had better memory, attention, and ability to do complex tasks. These people also had higher levels of nitrite in their mouths.
On the other hand, greater levels of the bacteria, Porphyromonas, were more common in individuals with memory problems.
Whereas the bacterial group Prevotella was linked to low nitrite, which the researchers predict could in turn mean poorer brain health and was more common in people who carry the Alzheimer’s Disease risk gene, APOE4.
Professor Anne Corbett, of the University of Exeter Medical School, said the findings may lead to solutions like “dietary changes, probiotics, oral hygiene routines, or even targeted treatments” to prevent dementia.
(Except for the headline, this story is not edited by Republic and is published from a syndicated feed.)
Published By : N. Lothungbeni Humtsoe
Published On: 6 February 2025 at 07:41 IST